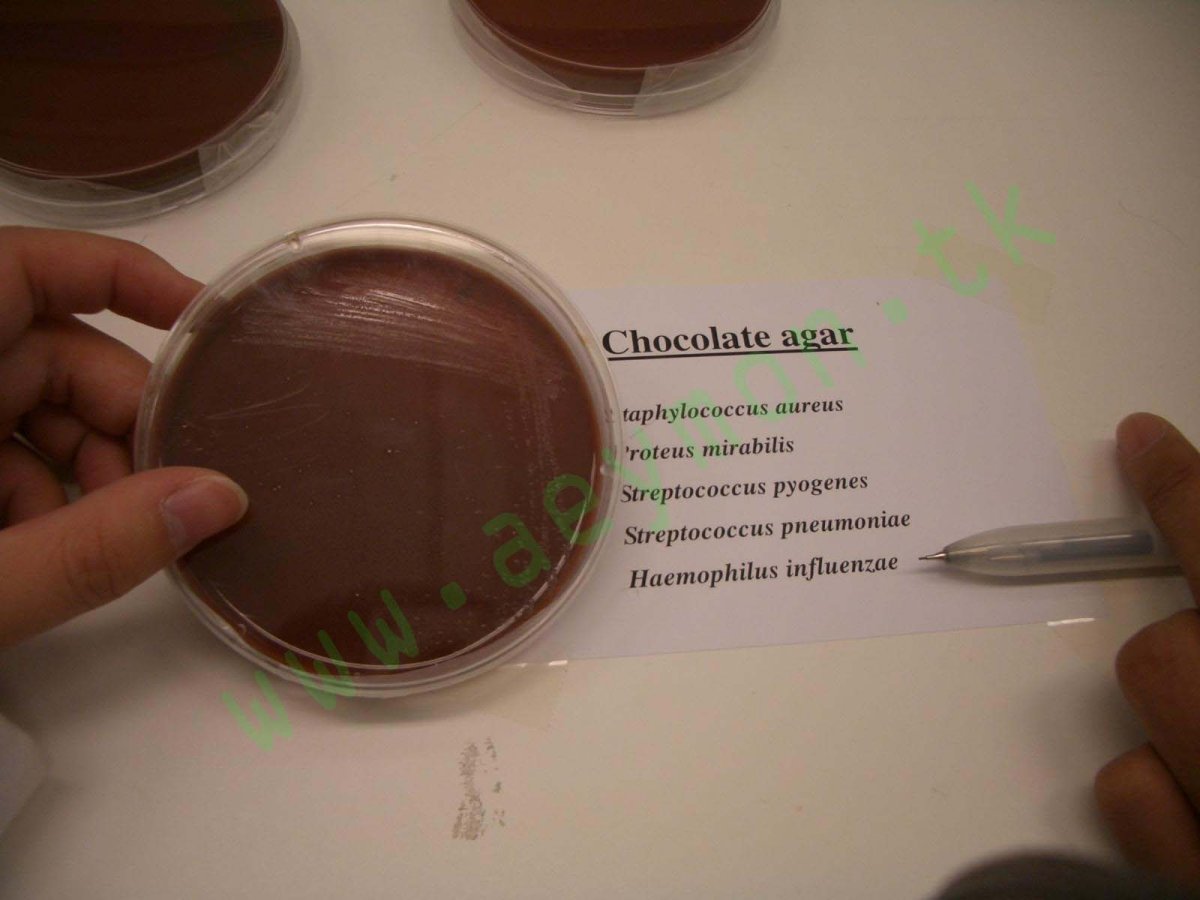

Мусс на агар агаре шоколадный
Мусс из темного шоколада
Шоколадный мусс
Десерты из шоколада
Торт муссовый клубничный чизкейк
Шоколадный мусс "Ашанти"
Шоколадный пудинг мусс
Шоколадный мусс с агар агаром
Панна котта
Панна котта с шоколадом
Муссовый чизкейк черная смородина
Панакота шоколадная
Шоколадный десерт
Панна-котта классический
Клубничный муссовый торт
Итальянская panna Cotta
Парфе Трайфл Панна котта
Глазурь Ежевичная
Суфле из агар-агара
Мусс на агаре
Мусс для торта
Десерт с желатином
Французский шоколадный мусс
Десерт Птичье молоко
Мусс Земляничный
Торт мусс три шоколада Добрынинский
Мусс с клубникой
Суфле Птичье молоко
Малиновый муссовый торт
Желе на агаре
Творожно шоколадный десерт
Мусс молочный шоколад
Панна-котта классический
Муссовый торт Брауни
Десерты желе молочное какао
Вишневый муссовый торт
Трайфл панакота
Kokes reseptler
Панна котта на агар агаре
Суфле Птичье молоко
Десерты из шоколада ресторанные
Mousse Welss шоколад
Маття чизкейк
Десерт с агар агаром
Муссовый торт манго черная смородина
Шоколадный десерт без выпечки с агаром какао с молоком и шоколадом
Желе в арбузе
Агар агар желе с клубникой
Панна котта Вишневая
Бланманже шоколадное
Торты с агаром
Десерт мусс Мишлен
Кофейное желе
Холодные и горячие Десерты
Мусс на темном шоколаде
Десерт panna Cotta
Медузье желе
Шоколадно творожное суфле
Творожное суфле с клюквой
Мусс ресторан
Шоколадный агар в микробиологии
Шоколадный мусс с какао
Желейные Десерты
ЖЕЛЕЙНЫЙ торт
Торт Птичье молоко на агар агаре
Десерт желе молочное
Украшение десертов
Морковная панакота
Десерт из киселя
Панна котта карамельная
Сложные горячие Десерты
Десерт с агар-агаром без выпечки с фруктами
Желейные Десерты
Изысканные Десерты
Шоколадное желе
Вишневый муссовый торт
Муссовый торт с зеркальной глазурью
Шоколадный мусс из какао
Творожный десерт бланманже
Мусс со сливками
Мусс на агар агаре шоколадный
Другие фото по теме::